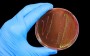

Notícias
Artigos publicados nesta seção. Exibindo página 306 de 307:
-
 Qual a função do Perito?
Para ser perito judicial é necessário estar vinculado ao conselho regional da sua categoria de formação. Conhecer bem a sua área de formação. Essa...
Qual a função do Perito?
Para ser perito judicial é necessário estar vinculado ao conselho regional da sua categoria de formação. Conhecer bem a sua área de formação. Essa...
-
 5ª Feira do Livro – USP Leste
De quarta-feira (12) até sexta feira (14) a Escola de Belas Artes e Humanidades da USP (Univerisade Cidade de São Paulo) promove a 5ª...
5ª Feira do Livro – USP Leste
De quarta-feira (12) até sexta feira (14) a Escola de Belas Artes e Humanidades da USP (Univerisade Cidade de São Paulo) promove a 5ª...
-
 Disciplinas unificadas
Sabe aquelas 13 disciplinas da escola? Elas serão serão divididas em quatro áreas de conhecimento. A futura mudança estudada pelo Ministério da Educação prevê...
Disciplinas unificadas
Sabe aquelas 13 disciplinas da escola? Elas serão serão divididas em quatro áreas de conhecimento. A futura mudança estudada pelo Ministério da Educação prevê...
-
 Projeto “De mão em mão” – Livros gratuitos
Projeto que distribui livros gratuitamente em terminais de ônibus. O Projeto “De mão em mão” nasceu em 2011 em parceria com a Fundação Editora...
Projeto “De mão em mão” – Livros gratuitos
Projeto que distribui livros gratuitamente em terminais de ônibus. O Projeto “De mão em mão” nasceu em 2011 em parceria com a Fundação Editora...
-
 Nutricionista
A profissão de foi criada pela Lei nº 5.276, em 24 de abril de 1967. Em 17 de setembro de 1991, a Lei nº...
Nutricionista
A profissão de foi criada pela Lei nº 5.276, em 24 de abril de 1967. Em 17 de setembro de 1991, a Lei nº...
-
Concurso cultural: Arte, Prevenção e Hepatites Virais
Todos sabem que o risco de se contrair Hepatite é muito comum atualmente, principalmente para profissionais que estão todos os dias “imunes” a essa...
Concurso cultural: Arte, Prevenção e Hepatites Virais
Todos sabem que o risco de se contrair Hepatite é muito comum atualmente, principalmente para profissionais que estão todos os dias “imunes” a essa...
-
 Globalização
INTRODUÇÃO Globalização é como um prisma que reflete várias realidades complexas. Intensifica múltiplas conexões entre governos e sociedades, entre público e privado, entre mercado...
Globalização
INTRODUÇÃO Globalização é como um prisma que reflete várias realidades complexas. Intensifica múltiplas conexões entre governos e sociedades, entre público e privado, entre mercado...
-
 Unicamp abre inscrições para Vestibular 2013
Quer prestar vestibular para Unicamp? Então, corre porque a Universidade Estadual de Campinas já abriu inscrições para o Vestibular do ano que vem. A...
Unicamp abre inscrições para Vestibular 2013
Quer prestar vestibular para Unicamp? Então, corre porque a Universidade Estadual de Campinas já abriu inscrições para o Vestibular do ano que vem. A...
-
 Feira do Estágio e Trainee
Por mais que faça teste ou leia sobre algumas profissões, muitos jovens ainda têm dúvidas sobre qual curso estudar e qual carreira seguir. Por...
Feira do Estágio e Trainee
Por mais que faça teste ou leia sobre algumas profissões, muitos jovens ainda têm dúvidas sobre qual curso estudar e qual carreira seguir. Por...
-
 22ª edição da Bienal Internacional do Livro de São Paulo
O tema da 22ª Bienal Internacional do livro de São Paulo é: “Livros transformam o mundo, livros transformam pessoas”. O evento acontecerá em São...
22ª edição da Bienal Internacional do Livro de São Paulo
O tema da 22ª Bienal Internacional do livro de São Paulo é: “Livros transformam o mundo, livros transformam pessoas”. O evento acontecerá em São...
-
 Brasil Sorridente
Até 2014 serão investidos mais de R$ 3,6 milhões. Um sorriso saudável e de qualidade é o que todos os brasileiros querem não é...
Brasil Sorridente
Até 2014 serão investidos mais de R$ 3,6 milhões. Um sorriso saudável e de qualidade é o que todos os brasileiros querem não é...
-
 Fim da Censura No Brasil
No dia 03 de agosto de 1988 acontece o fim da censura no Brasil.
Fim da Censura No Brasil
No dia 03 de agosto de 1988 acontece o fim da censura no Brasil.
-
 Jornalismo investigativo agora no Youtube
Foi anunciado nesta quinta-feira (02/08), pelo CIR (Centro de Reportagem investigativa) que o Youtube terá um canal exclusivo de jornalismo investigativo chamado “I Files”....
Jornalismo investigativo agora no Youtube
Foi anunciado nesta quinta-feira (02/08), pelo CIR (Centro de Reportagem investigativa) que o Youtube terá um canal exclusivo de jornalismo investigativo chamado “I Files”....
-
 Feira de Profissões – USP 2012
A Universidade Cidade de São Paulo realiza um evento a todos os estudantes de 2 a 4 de Agosto.
Feira de Profissões – USP 2012
A Universidade Cidade de São Paulo realiza um evento a todos os estudantes de 2 a 4 de Agosto.
-
 Facebook e Saúde
Facebook e Ministério da Saúde juntos na campanha de doação de órgãos.
Facebook e Saúde
Facebook e Ministério da Saúde juntos na campanha de doação de órgãos.
